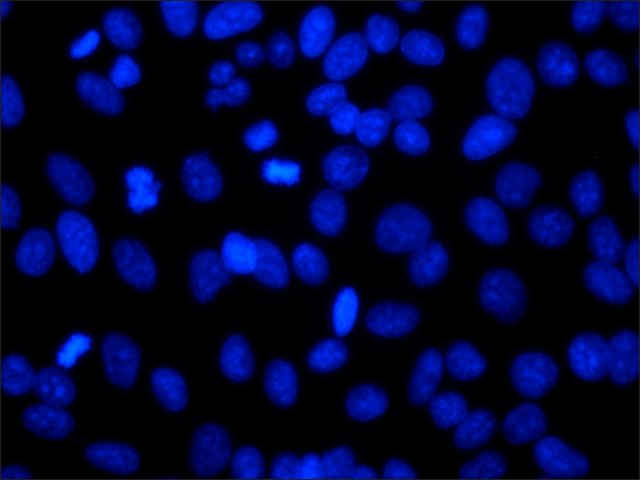

您的位置:首页 > 产品中心 > 23491-45-4, 双苯并咪唑 H 33258
双苯并咪唑 H 33258
Bisbenzimide H 33258
| 产品编号: | 3415352 |
| 规格: | powder, BioReagent, suitable for cell culture, ≥98% (HPLC and TLC) |
| CAS NO: | 23491-45-4 |
| 包装规格: | 25 MG,100 MG |
| 产品类别: | 进口试剂 |
| 品牌: | Sigma-Aldrich |
| 优惠价: | 立即咨询 |
产品价格查看更多规格...
| 产品编号 | 包装单位 | 单价(元) | 国内现货 | 国外库存 | 询价单 |
| 3415352 | 25 MG | 538 | |||
| 3415352 | 100 MG | 1340 |
产品别名
23491-45-4
双苯并咪唑 H 33258
Bisbenzimide H 33258
2′-(4-Hydroxyphenyl)-5-(4-methyl-1-piperazinyl)-2,5′-bi(1H-benzimidazole) trihydrochloride
BXI-72
BBIH
2-[2-(4-Hydroxyphenyl)-6-benzimidazoyl]-6-(1-methyl-4-piperazyl)benzimidazole trihydrochloride
Hoechst 33258
HOE 33258
NSC334072
烟酸己可碱 三盐酸盐
甲嗪双苯咪酚 三盐酸盐
结构式
基本信息
| Empirical Formula【经验(实验)分子式】 | C25H24N6O · 3HCl |
| Molecular weight | 533.88 |
| Beilstein | 4088183 |
| EC number【EC 号】 | 245-690-6 |
| MDL number | MFCD00012679 |
| PubChem Substance ID【PubChem化学物质编号】 | 24891565 |
| NACRES | NA.77 |
| Application【应用】 | bisBenzimide H 33258可用于DNA、染色体和细胞核的染色。 bisBenzimide H 33258可用于荧光显微术或流式细胞术。 最大激发波长= 346nm 最大发射波长= 460nm |
| Biochem/physiol Actions【生化/生理作用】 | bisBenzimide H 33258是一种有效的选择性Bcl-XL抑制剂。 bisBenzimide H 33258是一种膜可渗透的荧光DNA染色剂,具有低细胞毒性,可嵌入DNA的A-T区域。 |
产品性质
| Quality Level【质量水平】 | 200 |
| product line【产品线】 | BioReagent |
| Assay【测定】 | ≥98% (HPLC and TLC) |
| form【形式】 | powder |
| technique(s) | cell culture | mammalian: suitable |
| solubility【溶解性】 | H2O: 10 mg/mL water and ethanol: 10 mg/mL |
| suitability【适用性】 | passes application test for fluorescence |
| web metadata keyword.default | membrane permeable DNA stain, DNA-binding stain, flourescent DNA stain, chromosome stain |
| storage temp.【储存温度】 | −20℃ |
| SMILES string | Cl[H].Cl[H].Cl[H].[H]O[H].CN1CCN(CC1)c2ccc3NC(=NCc3c2)c4ccc5NC(=NCc5c4)c6ccc(O)cc6 |
| InChI | 1S/C27H28N6O.3ClH.H2O/c1-32-10-12-33(13-11-32)22-5-9-25-21(15-22)17-29-27(31-25)19-4-8-24-20(14-19)16-28-26(30-24)18-2-6-23(34)7-3-18;;;;/h2-9,14-15,34H,10-13,16-17H2,1H3,(H,28,30)(H,29,31);3*1H;1H2 |
| InChI key | OWRSPPSBNWJJAR-UHFFFAOYSA-N |
| packaging【包装】 | 25 mg in poly bottle 100 mg in glass bottle |
安全信息
| Storage Class Code【储存分类代码】 | 11 - Combustible Solids |
| WGK | WGK 3 |
| Personal Protective Equipment【个人防护装备】 | dust mask type N95 (US), Eyeshields, Gloves |





